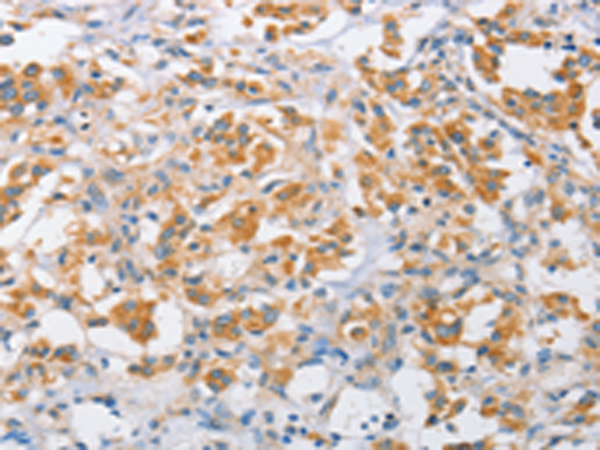
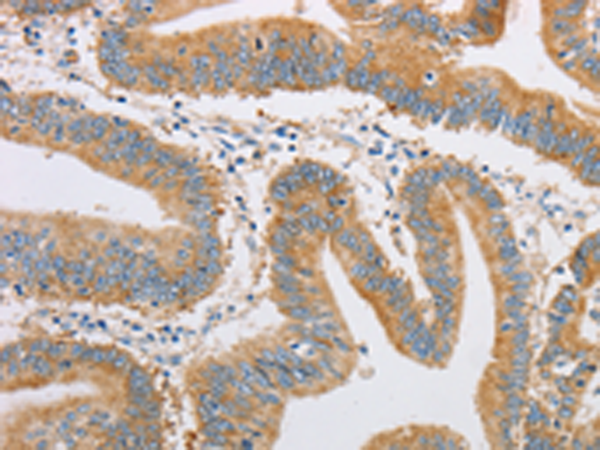

-
分类: 科研抗体货号: P07895别名: ALEX3; dJ545K15.2应用: WB,IHC反应种属: Human, Mouse, Rat
-
分类: 科研抗体货号: P07894别名: ALEX1应用: IHC反应种属: Human, Mouse, Rat
-
分类: 科研抗体货号: P07911别名:应用: IHC反应种属: Human, Mouse, Rat
-
分类: 科研抗体货号: P07892别名: ARL4应用: WB,IHC反应种属: Human, Mouse, Rat
-
分类: 科研抗体货号: P07930别名: RPL26P1应用: WB,IHC反应种属: Human
-
分类: 科研抗体货号: P07910别名: TSULF应用: IHC反应种属: Human, Mouse, Rat
-
分类: 科研抗体货号: P07891别名: HWNT11应用: IHC反应种属: Human, Mouse
-
分类: 科研抗体货号: P07929别名: CD283; IIAE2应用: IHC反应种属: Human
-
分类: 科研抗体货号: P07908别名: FRSB; PheHB; PheRS; FARSLB; HSPC173应用: IHC反应种属: Human, Mouse
-
分类: 科研抗体货号: P07890别名: ARHI; NOEY2应用: WB反应种属: Human, Rat

鄂公网安备42018502007531号
鄂公网安备42018502007531号

